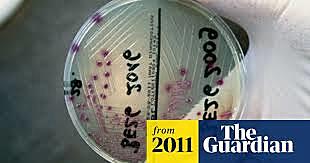
E coli outbreak

-
President George W. Bush wins the election. Al Gore loses the election.
-
I was only a year old when she passed.
-
First of the Apple products on the market
-
It was a moment of terror
-
Switzerland joins the United Nations
-
They stopped making cassette tapes
-
-
Homeland Security began operations and first opens its doors in 2003
-
It will be on the 18th season around 2021 due to the Covid 19 pandemic
-
Facebook is a social media site that is still used today
-
He dies from pneumonia
-
PSP (PlayStation Portable) was launched and I remember wanting one
-
He died of Parkinson’s disease when he was 84
-
Damaged a lot of parts of Louisiana and New Orleans
-
She is granted the Honorary Doctorate of Music degree from the Berklee College of Music.
-
The same person that created It, Pet Cemetery, and Cujo published his book Cell.
-
Gay Pride Parades were meant to support the LGBTQ+ community.
-
He was a american novelist who wrote Slaughterhouse-Five.
-
This is a video where there are two brothers and the youngest baby brother bites his older brother's finger.
-
Some of the early 2000 kid will know what a VHS tape is
-
Edward Kennedy announces his endorsement to Barack Obama in the 2008 election in Obama's first term.
-
Terrorist attack on the Danish Embassy
-
He was an American politician and a pro football player.
-
-
She graduates high school and goes to U of A.(The University of Arizona).
-
-
He was a post war jazz pianist.
-
They had ended up going bankrupt
-
They get married and Kate was a teacher so like a commoner.
-
It is a food born infection
-
Was meant for economic inequality
-
The first Hunger Games film of 5
-
-
Many people in the LGBTQ+ community were finally able to marry who they love legally.
-
Many were killed and injured.
-
RIP (Rest in Peace) he had committed suicide.
-
I was Promoted from middle school to high school
-
The Government Shutdown lasted about a month.
-
They were at a stand still
-
One dies in August and the other one dies in September
-
-
There was a search for it.
-
It is about the Carl Hayden H.S. Robotics Team beating MIT. It made people be proud of who they are and understand how hard it is to be an undocumented immigrant.
-
-
Happen at Adriana grades concert in Manchester in the UK
-
-
He was 69.
-
She was most known for her role in Star Wars as Princess Leia.
-
Mother and daughter are in heaven together.
-
Confederate monuments resembled slavery and white supremacy
-
-
Graduated high school went straight to phoenix comic con.
-
50 were killed 500 wounded
-
They get married
-
Famous singer dies at age 76
-
Impeaching Trump
-
-
A person who died in his sleep from a seizure. He had Epilepsy.
-
They should be proud role models
-
-
Face mask is started to be required everywhere. Stimulus checks go out.
-
Their was a start of a new era
-
Every where is shut down, and everyone must stay home unless you are an essential worker.
-
Looking for a timeline maker?
Create timelines for projects, roadmaps, history, lessons, legal cases, and stories with Timetoast. Timetoast is a timeline maker for work, school, research, and stories.